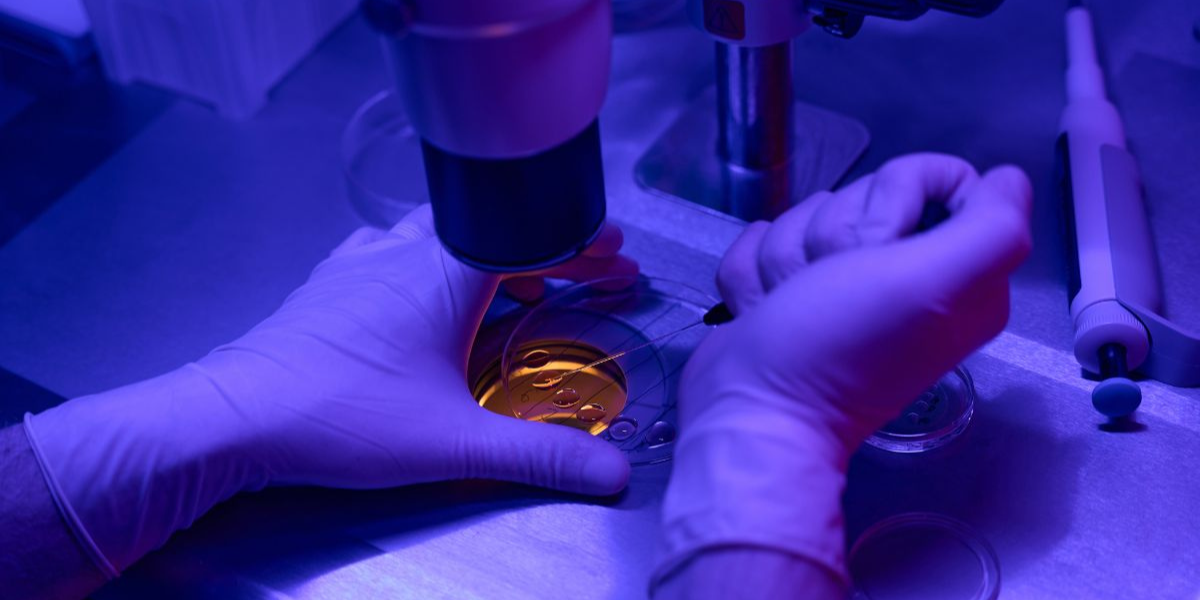
Preimplantation genetic testing consultation in Navi Mumbai at Sattva Fertility Care Center

What is Preimplantation Genetic Testing (PGT)?
Preimplantation Genetic Testing (PGT) refers to a set of diagnostic procedures performed on embryos before implantation. Its primary aim is to identify genetic defects within embryos created through IVF before pregnancy is established. PGT is subdivided into three main categories:
Explore Preimplantation Genetic Testing (PGT) with Dr. Priya Khamatkar in Navi Mumbai at Sattva Fertility Care Center. Ensure healthy embryo selection, Schedule a consultation today !
Why is PGT Used in IVF?
Advantages of Preimplantation Genetic Testing
The advantages of PGT are multifaceted, extending beyond the immediate benefits of genetic screening to broader implications for reproductive health and genetic research.